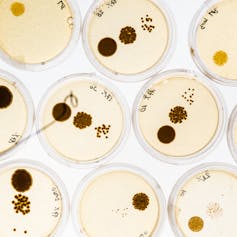

We’ve heard a lot lately about superbugs – bacteria that are resistant to current antibiotics. But as the threat of superbugs continues to rise, the number of new treatments available has flatlined. This has placed us dangerously close to the edge of a return to the pre-antibiotic era, when even simple infections caused death.
We’ve developed antibiotics in the past, so why it is now so difficult to discover and develop new antibiotics? To find out, let’s look back to the “golden age” of antibiotic discovery from the 1940 to 1970s.
How we found antibiotics in the past
The majority of antibiotics we use at home or in hospitals today have their origins in natural products.
The penicillins, cephalosporins, aminoglycosides, rifamycins, tetracyclines and glycopeptide-based antibiotics all came from bacteria or fungi. They were made by nature in response to selective evolutionary pressure over eons of “chemical warfare”, in which microorganisms battled to survive by killing off their competitors with antibiotics.
Of course, they also co-evolved resistance mechanisms to avoid being killed by their own compounds, so antibiotic resistance is equally ancient. Scientists have found antibiotic resistance genes in bacteria isolated from 30,000-year-old permafrost, long before antibiotics were discovered and used by humans.
Most antibiotics found during the “golden age” were from micro-organisms themselves, isolated from soil or plants and then cultured in the laboratory. They were easily screened on agar culture plates or liquid culture broths to see if they could kill pathogenic bugs.
The toolkit required was pretty simple: some dirt, a culture flask to grow the antibiotic-producing bacteria or fungi, a column to separate and isolate the potential new antibiotic, and a culture plate and incubator to test if the compound could kill a disease-causing pathogenic bacteria.
Chemists were then able to “tweak” these new structures to extend their activity against different bacteria and improve their ability to treat infection in the clinic. Most of the antibiotics we have are derived from just one soil-dwelling bacterial order – the Actinomycetales.

The problem is that by using this tried and trusted method over and over again, we have found all of the low-hanging fruit antibiotics. So scientists have been forced to look further afield, turning to coral reefs, deep oceans and cave-dwelling bacteria to search for new promising molecules.
Key challenges
Philosopher Sun Tzu said “the supreme art of war is to subdue the enemy without fighting”. We are now in a protracted war against superbugs, as we have overplayed a key weapon against disease. Our unfortunate misuse and abuse of antibiotics means that bacteria have developed new ways to inactivate the drugs, to stop them getting to their targets within the bacteria cells, and to pump them back out of the cell when they do get in.
The cost and time required to bring new drugs to market are staggering. Estimates for the time to bring a new antibiotic through the preclinical, clinical and regulatory approval process are in the order of 13 to 15 years and around US$1.2 billion. If the costs of failures are factored in, it is closer to US$2.5 billion.
Because we expect to pay $20 or at most $200 for a course of antibiotics (compared to more than $20,000 for many cancer treatments), and because we only take antibiotics for a week or two, almost all of the companies that were active in antibiotic discovery have left the field over the last 20 years.
What are scientists doing?
It’s not all doom and gloom. Scientists have developed many innovative approaches to the search for new antibiotics, such as one recently reported in Nature, in which bacteria from soil are sealed into 10,000 separate miniature culture cells in a chip device, then buried in the soil they came from again to grow in their natural environment. The chip device is then dug up, and each cell screened for compounds that can kill pathogenic bacteria.

This type of approach led to the discovery of one of the very few new candidate antibiotics in the last 30 years, teixobactin.
This type of innovation illustrates an important maxim: with good people, the right motivation, perseverance, and sufficient funding we can start to fix some of problems we face in this area.
What are governments doing?
Fortunately, governments around the world have started to respond.
British Prime Minister David Cameron and Chief Medical Officer Dame Sally Davis have been consistent vocal supporters of a cross-government strategy and action plan against superbugs. In fact, Dame Davies recognised that the threat from infections resistant to frontline antibiotics was so serious that she called for the issue to be added to the UK government’s national risk register of civil emergencies, alongside pandemic influenza and terrorism.
The European Union has stepped up with the Innovative Medicines Initiative (IMI), Europe’s largest public-private initiative aiming to speed up the development of better and safer medicines for patients. They have pledged more than €680 million (A$985 million) to fund drug-discovery platforms for antibiotics; new treatments for cystic fibrosis; hospital-acquired pneumonia and urinary tract infections; understanding how drugs get into, and then stay inside bacteria; and new ways of designing and implementing efficient clinical trials for novel antibiotics.

In the United States, the National Institutes of Health (NIH) invest more than US$5 billion (17% of total funds) into infectious diseases research, making it second only to cancer research at US$5.4 billion (18%). In a further show of support, US President Barack Obama also announced an Executive Order commanding a dozen government agencies to action a comprehensive action plan against superbugs.
So how are we doing in Australia? Infectious disease research for new antibiotics and diagnostic methods to identify superbugs is not yet an Australian national health priority area. In 2014, the Australian government, through the National Health and Medical Research Council, invested A$13.4 million into antibiotic development and resistance research, less than half of which was directed to discovery of new compounds. This equates to around 2% of the 2014 research budget.
We need better stewardship of existing antibiotics, better diagnostic methods and new antibiotics that we can take better care of this time around.
Unfortunately, we are dragging our feet in dealing with the superbug threat. This year, after more than 20 years of reviews and white papers, the Australian ministers for health and agriculture will be presented with comprehensive recommendations from leading clinicians, health-care workers, scientists, and policymakers about how we can work together to finally overcome the challenges of combating bacterial infections.
Yes, we’ve heard a lot lately about superbugs.
Now it’s time to act.

